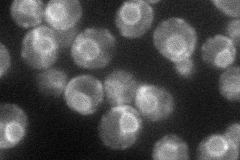
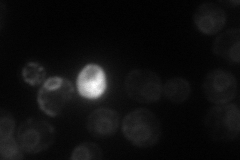
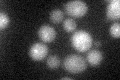

View description
Putative regulatory subunit of Nem1p-Spo7p phosphatase holoenzyme, regulates nuclear growth by controlling phospholipid biosynthesis, required for normal nuclear envelope morphology, premeiotic replication, and sporulation
Localization:
Intensity:
Fold change:
Significance:
-
C’ GFP library in SD

cytosol19.48 -
N' NOP1pr-GFP in SD
ER49.2783 -
N' TEF2pr-mCherry in SD
ER,vacuole34.5168 -
N' NATIVEpr-GFP in SD

below threshold22.5756 -
N' TEF2pr-VC and Cyto-VN in SD

below threshold29.2411 -
C’ GFP library in SD+DTT
cytosol20.891.07No -
C’ GFP library in SD+H2O2

cytosol19.561No -
C’ GFP library in Starvation Media

cytosol18.480.94No -
C’ GFP library on the background of Pup2-DaMP

cytosol -
C’ GFP library on the background of CCT mutant

cytosol19.95391.02369No
